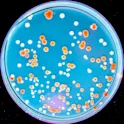

Environment
06 Oct 2021
Surprising discovery in Arctic songbird may reveal how it survives challenging migrations
By K.E.D Coan, science writer Snow buntings in winter. Image: Mircea Costina/Shutterstock.com There is still much to learn about how Arctic migratory birds adjust their physiology during different phases of their life. For example, between winter and summer habitats, or during migration. A recent study published to Frontiers shows the first evidence that snow buntings keep their winter traits through migration. These findings may help researchers understand why snow bunting populations are declining, as well as expanding what is known about how buntings, and other species, endure Arctic weather. Snow buntings are equipped for winter even while migrating to their breeding grounds, shows a recent study in Frontiers in Ecology and Evolution. There have been major declines in biodiversity around the world and the snow bunting population has dropped 60% over the last 45 years. The specific cause of this drop is unknown, and this study is among the first to look at the physiological changes that occur during the different life stages of this species (ie between winter and migration). This work provides clues into the future survival of snow buntings, as well as new insights into how species generally endure the harsh cold of the Arctic. ► Read original […]